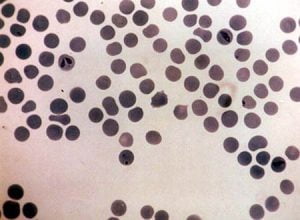

Welcome to Veepro Holland
- Akabene virus infection
- Antrax
- Babesiosis
- Bacillary Hemoglobinuria or Red Water Disease
- Bluetongue
- Bovine Ephemeral Fevert
- Bovine Genital Campylobacteriosis
- Bovine Herpesvirus Type 1
- Bovine Leukosis
- Bovine Spongiform Encephalopathy
- Bovine Viral Diarrhea
- Brucellosis
- Contagious Bovine Pleuropleumonia
- East Coast Fever
- Foot- and- Mouth Disease
- Footrot
- Heartwater
- Infectious Keratoconjunctivitis
- Johnes Disease
- Leptospirosis
- Lumpy skin disease
- MCF or Snotsiekte
- Mucosal Disease
- Neosporosis
- Pneumonic Pasteurellosis
- Pseudocowpox
- Q Fever
- Rabies
- Rift Valley Fever
- Rinderpest
- Schmallenberg virus
- Shipping fever pneumonia
- Tickborne fever or Pasture fever
- Tuberculosis
- Vesicular stomatitis
Akabene virus infection
Akabane disease of cattle, sheep and goats is caused by infection with Akabane virus, a Bunyavirus. Akabane is an insect-transmitted virus, spread by Culicoides, that causes congenital abnormalities of the central nervous system in ruminants. Reported from the Far East, Australia, the Middle East and Africa. Infection of the dam causes abortion or defects in the fetus, with skeletal abnormalities and hydranencephaly as the principle findings in fetuses and newborn. The signs other than abortion and decreased milk yield are listed below and are seen in the offspring, not the mother. The Bunyavirus Aino virus belongs to the same genus as Akabane virus and is a potential teratogenic pathogen that has been serologically linked to congenital malformations in Japanese calves.
Diseases due to Akabane virus have been recognized in Australia, Israel, Japan, and Korea; antibodies to it have been found in a number of countries in southeast Asia, the Middle East, and Africa. The disease affects fetuses of cattle, sheep, and goats. Asymptomatic infection has been demonstrated serologically in horses, buffalo, and deer (but not in humans or pigs) in endemic areas.
Bovine calf: the head is hyperextended. The limb joints are fixed and vary from hypercontracted to hyperextended.

Antrax
Also termed splenic fever, Siberian ulcer, Charbon or Milzbrand. Anthrax is a zoonotic disease caused by the sporeforming bacterium Bacillus anthracis of sheep, horses, cattle, and other herbivorous animals. Historically, the disease in humans has been restricted mainly to people who work with animals, or animal products. However, recent episodes have brought attention to the causative agent of anthrax, Bacillus anthracis. This pathogenic organism produces spores when environmentally stressed. These spores, which contain the genetic material of the bacteria, encased in a tough coat, are highly resistant to harsh environmental conditions such as drying, heat and starvation.
There are reports of anthrax spores remaining viable for over 50 years in soil. Spores can germinate and form the vegetative, disease-producing form when environmental conditions are favorable. The spore-forming characteristic, and the fact that the bacteria, unlike most spore-forming pathogenic bacteria, can readily grow in the presence of oxygen, has made Bacillus anthracis one of the top choices as a biological warfare agent. Anthrax is most common in wild and domestic herbivores, but can also be seen in humans exposed to tissue from infected animals, contaminated animal products or directly to B anthracis spores under certain conditions.
Depending on the route of infection, host factors, and potentially strain-specific factors, anthrax can have several different clinical presentations. In herbivores, anthrax commonly presents as an acute septicemia with a high fatality rate, often accompanied by hemorrhagic lymphadenitis. In dogs, humans, horses, and pigs, it is usually less acute. B anthracis spores can remain infective in soil for many years. During this time, they are a potential source of infection for grazing livestock, but generally do not represent a direct infection risk for humans. Grazing animals may become infected when they ingest sufficient quantities of these spores from the soil. In addition to direct transmission, biting flies may mechanically transmit B anthracis spores from one animal to another.
The relative importance of this mode of transmission during epizootics or epidemics has yet to be quantified, but is frequently suspected. Feed contaminated with bone or other meal from infected animals can serve as a source of infection for livestock, as can hay that is heavily contaminated with infected soil. Raw or poorly cooked contaminated meat is a source of infection for carnivores and omnivores; anthrax resulting from contaminated meat consumption has been reported in pigs, dogs, cats, mink, wild carnivores, and humans.
Babesiosis
Also called piroplasmosis, Texas Fever, Redwater of Tick Fever. Babesiosis is caused by intra-erythrocytic protozoan parasites of the genus Babesia. The disease, which is transmitted by ticks, affects a wide range of domestic and wild animals and occasionally humans. While the major economic impact of Babesiosis is on the cattle industry, infections in other domestic animals, including horses, sheep, goats, pigs, and dogs, assume varying degrees of importance throughout the world. Two important species in cattle are B bigemina and B bovis.
Bacillary Hemoglobinuria or Red Water Disease
Bacillary hemoglobinuria is an acute, infectious, toxemic disease caused by Clostridium Haemolyticum C type D. It affects primarily cattle but has also been found in sheep and rarely in dogs. It occurs in the western part of the USA, along the Gulf of Mexico, in Venezuela, Chile, Great Britain, the middle East, and other parts of the world. Cattle may be found dead without premonitory signs. Usually, there is a sudden onset of severe depression, fever, abdominal pain, dyspnea, dysentery, and hemoglobinuria. Anemia and jaundice are present in varying degrees. Edema of the brisket may occur. HGB and RBC levels are quite low. The duration of clinical signs varies from about 12 hours in pregnant cows to about 3 to 4 days in other cattle.
The mortality in untreated animals is about 95%. Some cattle suffer from subclinical attacks of the disease and thereafter act as immune carriers. The general clinical picture usually permits a diagnosis. The most striking sign is the typical port-wine-colored urine, which foams freely when voided or on agitation. The presence of the typical liver infarct is sufficient for a presumptive diagnosis. The normal size and consistency of the spleen serve to exclude anthrax and anaplasmosis. Bracken fern poisoning and leptospirosis also should be considered. Diagnosis can be confirmed by isolating C haemolyticum from the liver infarct, but the organism is difficult to culture. Rapid and accurate diagnosis can be made by demonstrating the organism in the liver tissue by a fluorescent antibody or immunohistochemical test or by demonstrating the toxin in the fluid in the peritoneal cavity or in a saline extract of the infarct.
Bluetongue
Bluetongue is an infectious, noncontagious arthropodborne viral disease primarily of domestic and wild ruminants. Infection with bluetongue virus is common worldwide but is usually subclinical or mild in most infected ruminants. Bluetongue is characterized by inflammation of mucous membranes, congestion, swelling and hemorrhages. Bluetongue is almost exclusively a disease of sheep, particularly the fine-wool and mutton breeds, although white-tailed deer, pronghorn and desert bighorn sheep may develop severe clinical disease in North America. Cattle have milder symptoms. In some parts of the world, infection without clinical disease is recognized.
Bluetongue is spread by small biting midges. It is not transmitted by direct or indirect contact between animals in the absence of the insects. Rarely virus may be excreted in the semen when males are viraemic. Contaminated semen may infect recipient cows, but would be unlikely to establish in an area unless abundant vectors were present. Tentative diagnosis of BT can be made when clinical signs appear in populations known to be susceptible, the occurrence of disease coincides with a prevalence of insect vectors, necropsy of sheep reveals characteristic gross lesions, and a flock history of recent wasting (loss of weight) and pododermatitis (foot rot).
The typical clinical signs of bluetongue enable a presumptive diagnosis, especially in areas where the disease is endemic. Suspicion is confirmed by the presence of petechiae, ecchymoses, or hemorrhages in the wall of the base of the pulmonary artery and focal necrosis of the papillary muscle of the left ventricle. These highly characteristic lesions are usually obvious in severe clinical infections but may be barely visible in mild or convalescent cases. These lesions are often described as pathognomonic for bluetongue, but they have also been observed occasionally in other ovine diseases such as heartwater, pulpy kidney disease, and Rift Valley fever.
Bovine Ephemeral Fevert
It’s a non-contagious disease of cattle caused by bovine ephemeral fever virus. The virus has been isolated from various species of midges and mosquitoes which are probably the main vectors. The virus is present in Africa, the Middle East, Asia, and Oceania. Clinically-affected cattle are generally 6 months to 2 years of age but all ages are susceptible. Signs are usually mild and last for just a few days but high morbidity can cause loss of milk in dairy herds making this an important viral diseases of cattle.
Signs, which occur suddenly and vary in severity, include biphasic to polyphasic fever, shivering, inappetence, lacrimation, serous nasal discharge, drooling, dyspnea, atony of forestomachs, depression, stiffness and lameness, and a sudden decrease in milk yield. Affected cattle may become recumbent and paralyzed for 8 hours to 1 week. After recovery, milk production often fails to return to normal levels until the next lactation. Abortion, with total loss of the season’s lactation, occurs in about 5% of cows pregnant along 8 to 9 months.
The virus does not appear to cross the placenta or affect the fertility of the cow. Bulls, heavy cattle, and high-lactating dairy cows are the most severely affected, but spontaneous recovery usually occurs within a few days. More insidious losses may result from decreased muscle mass and lowered fertility in bulls. Single cases are difficult to diagnose, but with a herd outbreak, when cattle at various stages of disease can be examined, diagnosis is made from clinical observations and the history of the outbreak.
Bovine Genital Campylobacteriosis
Bovine genital campylobacteriosis is a venereal disease of cattle characterized primarily by early embryonic death, infertility, a protracted calving season, and occasionally abortion. Distribution is worldwide. Cows are systemically normal, but there is a variable degree of mucopurulent endometritis that causes early embryonic death, prolonged luteal phases, irregular estrous cycles, repeat breeding and, as a result, protracted calving periods, assuming the breeding season is long enough to allow for complete clearance and a successful rebreeding.
Observed abortions are not common. In herds not managed intensively, disease may be noticed only when pregnancy examinations reveal low or marginally low pregnancy rates but, more importantly, great variations in gestation lengths, especially when the disease has recently been introduced to the herd. In subsequent years, infertility is usually confined to replacement heifers and a few susceptible cows. Bulls are asymptomatic and produce normal semen. Campylobacteriosis and Trichomoniasis are similar syndromes, and investigations should be directed at both diseases.
Bovine Herpesvirus Type 1
Infectious bovine rhinotracheitis is caused by BHV 1. It often presents as respiratory disease, but cows that had no respiratory signs can abort. Conjunctival signs of Infectious Bovine Rhinotracheiti (IBR) infection can present with no respiratory signs or abortions. Corneal opacities start peripherally. Young calves can develop a generalized disease due to IBR.
Infectious pustular vulvovaginitis is the genital form of IBR infection caused by Herpesvirus 1 Type 2b. Main lesions are small papules and pustules on the mucosa of the vulva and vagina in females and the penis in males. Usually, but not always, seen without concurrent respiratory disease. The incubation period for the respiratory and genital forms is 2 to 6 days. In the respiratory form, clinical signs range from mild to severe, depending on the presence of secondary bacterial pneumonia. Clinical signs include high fever, anorexia, coughing, excessive salivation, nasal discharge that progresses from serous to mucopurulent, conjunctivitis with lacrimal discharge, inflamed nares (hence the common name ‘red nose’), and dyspnea if the larynx becomes occluded with purulent material.
Nasal lesions consist of numerous clusters of grayish necrotic foci on the mucous membrane of the septal mucosa, just visible inside the external nares. They may later be accompanied by pseudo diphtheritic yellowish plaques. Conjunctivitis with corneal opacity may occur as the only manifestation of BHV 1 infection. In the absence of bacterial pneumonia, recovery generally occurs 4 to 5 days after the onset of signs. Abortions may occur concurrently with respiratory disease but may be seen up to 100 days after infection. They can occur regardless of the severity of disease in the dam. Abortions generally occur during the second half of pregnancy, but early embryonic death is possible. In genital infections, the first signs are frequent urination, elevation of the tail head, and a mild vaginal discharge. The vulva is swollen, and small papules, then erosions and ulcers, are present on the mucosal surface. If secondary bacterial infections do not occur, animals recover in 10 to 14 days. With bacterial infection, there may be inflammation of the uterus and transient infertility, with purulent vaginal discharge for several weeks. In bulls, similar lesions occur on the penis and prepuce BHV-1 infection can be severe in young calves and cause a generalized disease. Pyrexia, ocular and nasal discharges, respiratory distress, diarrhea, incoordination, and eventually convulsions and death may occur in a short period after generalized viral infection. Uncomplicated BHV 1 infections can be diagnosed based on the characteristic signs and lesions. However, because the severity of disease can vary, it is best to differentiate BHV 1 from other viral infections by viral isolation.
Bovine Leukosis
Also termed Bovine Lymphosarcoma, Leukemia or Malignant Lymphoma. Enzootic bovine leukosis is a viral disease of adult cattle characterized by neoplasia of lymphocytes and lymph nodes. The prevalence of infection in a herd may be high, but only a few animals develop fatal lymphosarcoma. Infection is spread by contact with contaminated blood from an infected animal. Sporadic bovine leukosis consists of juvenile, thymic, and cutaneous lymphosarcomas. These may resemble enzootic bovine leukosis, but affected animals are seronegative for bovine leukemia virus (BLV).
Outbreaks of lymphosarcoma in sheep have been observed with clinical, epidemiologic, hematologic, and necropsy findings similar to those of enzootic bovine leukosis. Infection of other species with BLV has not been demonstrated. Epidemic occurrences of lymphosarcoma have been observed in pigs. Cases in horses are sporadic. Tumors from BLV are commonly found in the uterus, abomasum, heart and external lymph nodes. The usual incubation period is 4 to 5 years. Persistent lymphocytosis without clinical signs occurs earlier, but rarely before 2 years of age. Many cows remain in the preclinical stage for years, often for their complete productive lifetime, without any apparent reduction in performance. In 5 to 10% of clinical cases the course is peracute; often affected animals die suddenly without prior evidence of illness. Involvement of the adrenal glands, rupture of an abomasal ulcer, or an affected spleen followed by acute internal hemorrhage are known causes. In most clinical cases, the course is subacute (up to 7 days) to chronic (several months) and initiated by an unexplainable loss of body condition, anorexia, pallor, and muscular weakness. Production may drop abruptly in dairy cows. The heart rate is not increased unless the myocardium is involved, and the temperature is normal unless tumor growth is rapid and extensive, when it rises to 103 to 104°F (39.5 to 40°C). Once signs of clinical illness and tumor development are detectable, the course is rapid and death occurs in 2 to 3 weeks. The superficial lymph nodes enlarge in 75 to 90% of cases, and this is often an early clinical finding. It is usually accompanied by small (1 cm diameter) subcutaneous lesions, often on the flanks and perineum.
However, peripheral lesions may be completely absent in many cases with advanced visceral involvement. Enlargement of visceral lymph nodes is common, but this is usually subclinical unless they compress other organs such as intestine or nerves. They may be palpable on rectal examination, and special attention should be given to the deep inguinal and iliac nodes. In advanced cases, extensive spread to the peritoneum and pelvic viscera occurs, and the tumor masses are easily palpable. The enlargement may be confined to the pelvic nodes or to one or more subcutaneous nodes. Involvement of the nodes of the head is sometimes observed, often with exophthalmos. The affected nodes are smooth and resilient; in dairy cows, they are easily seen and may be marked by local edema.
Occasionally, the entire body surface is covered with subcutaneous masses 5 to 11 cm in diameter. In addition to the lymph nodes, tissues most commonly affected include the abomasum, heart, spleen, kidneys, uterus, spinal meninges, and retrobulbar lymphatic tissue. Heart sounds are commonly muffled, and other cardiac abnormalities may be obvious. Neural lymphomatosis may lead to the gradual onset of posterior paralysis over several weeks. Because of the wide range of clinical findings, a definitive diagnosis is often difficult. Enlargement of peripheral lymph nodes without fever or lymphangitis is unusual in other diseases, except for tuberculosis, which can be differentiated by the tuberculin test.
Bovine Spongiform Encephalopathy or Mad Cow Disease
Bovine spongiform encephalopathy (BSE) is a progressive, fatal, neurologic disease of adult domestic cattle that resembles scrapie of sheep and. It was first diagnosed in Britain in 1986. BSE has been transmitted experimentally to mice, pigs, sheep, goats, cattle, mink, Macaque monkeys, and marmosets. During the epidemic of BSE in Great Britain, small numbers of cases of spongiform encephalopathy were seen in several species of captive bred ungulates and in 5 species of felids either kept in or originating from British zoologic collections.
A low incidence has been seen in domestic cats in the British Isles, with one isolated case in Norway. The ungulates were infected from the same foodborne source as cattle, and all species of felids were most likely infected by consuming infected bovine tissues. BSE is associated with accumulation of protease-resistant prion protein (PrP). There is an insidious onset of signs which generally leads to slaughter in 1 week to 14 months.
Histopathologic examination shows bilaterally symmetrical degenerative changes in brain stem grey matter with discrete ovoid and spherical vacuoles and microcavities in the neuropil. Only the UK has experienced a significant epidemic that, at its peak at the end of 1992, represented an annual incidence of about 1% of adult cattle. Lower incidences have been seen in indigenous cattle in Ireland, France, Switzerland, the Netherlands, Portugal, Germany, Denmark, Italy, Spain, Austria, Belgium, the Czech Republic, Finland, Greece, Israel, Japan, Liechtenstein, Luxembourg, Poland, Canada, Slovakia, and Slovenia. BSE has been detected in the majority of these countries as a result of active surveillance. Cases in animals exported from Great Britain have been seen in Canada, the Falkland Islands, and the Sultanate of Oman. Cattle populations in other countries may have become infected as a result of the importation of cattle and/or ruminant-derived meat and bone meal from countries with the disease.
Bovine Viral Diarrhea and Mucosal Disease Complex
Disease induced by BVD virus varies in severity, duration, and organ systems involved. Acute disease results from infection of susceptible cattle with either noncytopathic or cytopathic BVDV. Acute BVD, also termed transient BVD, often is an unapparent to mild disease of high morbidity and low mortality. Biphasic fever (104°F [40°C]), depression, decreased milk production, transient inappetence, rapid respiration, excessive nasal secretion, excessive lacrimation, and diarrhea are typical signs of acute BVD. Clinical signs of disease usually are seen 6 to 12 days after infection and last 1 to 3 days.
Transient leukopenia may be seen with onset of signs of disease. Recovery is rapid and coincides with production of viral neutralizing antibody. Gross lesions seldom are seen in cases of mild disease. Lymphoid tissue is a primary target for replication of BVDV, which may lead to immunosuppression and enhanced severity of intercurrent infections. Some isolates of BVDV induce clinically severe disease that manifests as oral ulcerations, eruptive lesions of the coronary band and interdigital cleft, diarrhea, dehydration, leukopenia, and thrombocytopenia. In thrombocytopenic cattle, petechial hemorrhages may be seen in the conjunctiva, sclera, nictitating membrane of the eyes; and on mucosal surfaces of the mouth and vulva.
Prolonged bleeding from injection sites also occurs. High morbidity with moderate mortality is common. Severity of acute BVD is related to the virulence of the viral strain infecting the animal and does not depend on viral biotype or genotype. In pregnant cattle, BVDV may cross the placental barrier and infect the fetus. The consequences of fetal infection usually are seen several weeks to months after infection of the dam and depend on the stage of fetal development and on the strain of BVDV. Infection of the dam near the time of fertilization may result in reduced conception rates. Infection during the first 4 months of fetal development may lead to embryonic resorption, abortion, growth retardation, or persistent infection. Congenital malformations of the eye and CNS result from fetal infections that occur between months 4 to 6 of development. Fetal mummification, premature birth, stillbirth, and birth of weak calves also are seen after fetal infection. Persistent infection is an important sequela of fetal infection with noncytopathic BVDV. Persistently infected calves may appear healthy and normal in size, or they may show stunted growth and be prone to respiratory or enteric ailments. They often have a short lifespan, and death before 2 years of age is common. Persistently infected cows give birth to persistently infected calves, but most calves sired by a persistently infected bull will not be infected with virus in utero.
Lesions attributable to BVDV often are not seen in persistently infected cattle at necropsy. Antibody against BVD seldom is detected in persistently infected cattle in the absence of vaccination or superinfection with an antigenically heterologous BVDV. Persistently infected cattle exposed to BVDV that is antigenically different from their resident noncytopathic virus can produce antiviral antibody. Therefore, screening for persistent infection using the viral neutralization test to identify animals that lack antiviral antibody may not detect some persistently infected cattle.
Brucellosis
Also called Bang’s Disease, Brucella abortus is a major cause of abortion worldwide but has been controlled in most parts of the world. In countries with a high incidence of bovine brucellosis B. Melitensis is sometimes isolated from cattle. Most abortions occur at 6 to 8 months of gestation. Can rarely cause hygromas of the limbs or supraspinous bursa in cattle or infect the reproductive tract of bulls.
Arthritis has also been reported. Abortion is the most obvious manifestation. Infections may also cause stillborn or weak calves, retained placentas, and reduced milk yield. Usually, general health is not impaired in uncomplicated abortions. Seminal vesicles, ampullae, testicles, and epididymides may be infected in bulls; therefore, organisms are present in the semen. Agglutinins may be demonstrated in seminal plasma from infected bulls.
Diagnosis is based on bacteriology or serology. B. abortus can be recovered from the placenta but more conveniently in pure culture from the stomach and lungs of an aborted fetus. Most cows cease shedding organisms from the genital tract when uterine involution is complete. Foci of infection remain in some parts of the reticuloendothelial system, especially supramammary lymph nodes, and in the udder. B. abortus can frequently be isolated from secretions of nonlactating udders.
Contagious Bovine Pleuropleumonia
This highly contagious pneumonia is generally accompanied by pleurisy. It is present in Africa, the Iberian peninsula, and parts of India and China; minor outbreaks occur in the Middle East. In acute cases, signs include fever up to 107°F (41.5°C), anorexia, and painful, difficult breathing. In hot climates, the animal often stands by itself in the shade, its head lowered and extended, its back slightly arched, and its elbows turned out.
Percussion of the chest is painful; respiration is rapid, shallow, and abdominal. If the animal is forced to move quickly, the breathing becomes more distressed and a soft, moist cough may result. The disease progresses rapidly, animals lose condition, and breathing becomes very labored, with a grunt at expiration. The animal becomes recumbent and dies after 1 to 3 weeks. Chronically affected cattle usually exhibit signs of varying intensity for 3 to 4 weeks, after which the lesions gradually resolve and the animals appear to recover. Subclinical cases occur and may be important as carriers.
Diagnosis is based on clinical signs, complement fixation test, and necropsy. Confirmation is by histopathology. As soon as an outbreak is suspected, slaughter and necropsy of presumptively infected cattle is advisable.
East Coast Fever
East Coast fever (ECF), an acute disease of cattle, is usually characterized by high fever, swelling of the lymph nodes, dyspnea, and high mortality. It’s a form of bovine theileriosis, is a tick-transmitted protozoal, Theileria parva and a serious problem in east and central Africa. The first clinical sign of ECF in cattle appears 7 to 15 days after attachment of infected ticks. This is seen as a swelling of the draining lymph node, usually the parotid, for the ear is the preferred feeding site of the vector. This is followed by a generalized lymphadenopathy in which superficial subcutaneous lymph nodes such as the parotid, prescapular, and prefemoral lymph nodes, can easily be seen and palpated.
In ECF there is generalized lymphadenopathy; note the prescapular lymph node. Fever ensues and continues throughout the course of infection. This rise in temperature is rapid and is usually in excess of 103°F (39.5°C) but may reach 106°F (42°C). Anorexia develops, and loss of condition follows. Other clinical signs may include lacrimation, corneal opacity, nasal discharge, terminal dyspnea, and diarrhea. Before death the animal is usually recumbent, the temperature falls, and there is a severe dyspnea due to pulmonary edema that is frequently seen as a frothy nasal discharge. Death usually occurs 18 to 30 days after infestation of susceptible cattle by infected ticks. Mortality in fully susceptible cattle can be nearly 100 percent. The severity and time course of the disease depends on, among other factors, the magnitude of the infected tick challenge, for ECF is a dose- dependent disease, and on the strain of parasites. Some stocks of parasites cause a chronic wasting disease.
A fatal condition called “turning sickness” is associated with the blocking of brain capillaries by infected cells and results in neurological signs. In recovered cattle, chronic disease problems can occur that result in stunted growth in calves and lack of productivity in adult cattle. However, this syndrome tends to be in the minority of recovered clinical cases; in a majority of cases, asymptomatic carriers can be recognized with apparently little or no effect on their productivity.
An occult phase of 5 to 10 days follows before infected lymphocytes can be detected in Giemsa-stained smears of cells aspirated from the local draining lymph node. Subsequently, the number of parasitized cells increases rapidly throughout the lymphoid system, and from about day 14 onwards, cells undergoing merogony are observed. This is associated with widespread lymphocytolysis, marked lymphoid depletion, and leukopenia. Piroplasms in RBC infected by the resultant merozoites assume various forms, but typically they are small and rod-shaped or oval. ECF is only found in association with its known tick vectors, Rhipicephalus appendiculatus, R. zembeziensis and possibly R. duttoni and R. nitens. In many epidemiological situations, high mortality occurs only in calves; the adult cattle represent immune survivors. In the field, diagnosis is usually achieved by finding Theileria parasites in Giemsa-stained blood smears and lymph node needle biopsy smears.
Foot- and- Mouth Disease
Foot-and-mouth disease (FMD) is a highly contagious viral disease of cloven-hoofed animals. The disease is characterized by fever and the formation of vesicles (fluid-filled blisters) and erosions in the mouth, nose, teats and feet. Although not very lethal in adult animals, it causes serious production losses and is a major constraint in international trade.
The FMD situation has improved markedly in recent years particularly in Europe and some countries in south east Asia and South America. However, the disease remains endemic and at a high prevalence in many countries in Africa, the Middle East, Asia and South America. Europe, North and Central America, Pacific nations and the Caribbean are free of the disease. In a susceptible population, morbidity approaches 100%.
The disease is rarely fatal except in young animals. All species of deer and antelope, elephant, and giraffe are susceptible to FMD, but Old World camels are resistant to natural infection. South American camelids such as alpacas and llamas, although susceptible, are probably of no epidemiologic significance. Rats, mice, and guinea pigs can be infected experimentally.
Footrot
Also called Interdigital Phlemon or Foul in the Foot. Signs of foot rot include swelling of the coronary band with spreading of the toes and/or necrosis of tissue between the toes. Caused by a combination of anaerobic bacteria. Untreated cases often develop secondary joint and tendon sheath infection. Footrot is a subacute or acute necrotic infection originating from a lesion in the interdigital skin that leads to a cellulitis in the digital region. Pain, severe lameness, fever, anorexia, loss of condition, and reduced milk production are major signs of the disease.
Footrot has a worldwide distribution and is usually sporadic but may be endemic in intensive beef or dairy cattle production units. The incidence varies according to weather, season of year, grazing periods, and housing system. On average, footrot accounts for around 15% of claw diseases. The fore- or, more commonly, the hindlimbs can be affected, but more than one foot is rarely involved at the same time in mature cows. However, footrot can occasionally develop in several feet in calves. The first sign is swelling and erythema of the soft tissues of the interdigital space and the adjacent coronary band. The inflammation may extend to the pastern and fetlock. Typically, the claws are markedly separated, and the inflammatory edema is uniformly distributed between the 2 digits. In severe cases, the animal is reluctant to bear weight on the affected foot.
The skin of the interdigital space first appears discolored; later, it fragments with exudate production. As necrosis of the skin progresses, sloughing of tissue is likely to follow. A characteristic foul odor is produced.
Heartwater
Heartwater is a major infectious, noncontagious, rickettsial disease of ruminants in areas infested by ticks, mainly in Africa and the Caribbean. It’s caused by Ehrlichia ruminantium, an obligate-intracellular gram-negative bacterium spread by Amblyomma genus ticks. This disease can present in a peracute, acute, subacute, or clinically inapparent form; in the common acute form mortality is high.
Main lesions are hydropericardium and hydrothorax. Many ruminants, including some antelope species, are susceptible. Some animals may become subclinically infected and act as reservoirs. Indigenous African cattle breeds (Bos indicus) appear more resistant than B taurus breeds. Peracute disease is usually seen in Africa in nonnative breeds of sheep, cattle, and goats. Heavily pregnant cows are particularly susceptible to this form. The clinical signs may include a fever, severe respiratory distress, hyperesthesia, lacrimation, terminal convulsions, and sudden death. Some breeds of cattle, including Jerseys and Guernseys, may develop severe diarrhea as well.
The peracute form of heartwater is relatively rare, the most common form of heartwater is the acute form. This syndrome is seen in both nonnative and indigenous cattle, sheep, and goats. The symptoms begin with a sudden fever (up to 42°C), anorexia, listlessness, and rapid respiration. Occasionally, animals also have diarrhea. These symptoms are followed by nervous signs, particularly chewing movements, protrusion of the tongue, twitching of the eyelids, and circling, often with a high stepping gait. Affected animals sometimes stand with their heads lowered and legs apart. Some animals may become aggressive or anxious. As the disease progresses, the neurologic signs become more severe, and the animal goes into convulsions. In the terminal stages, galloping movements, opisthotonos, hyperesthesia, nystagmus and frothing at the mouth are common. Animals with the acute form of heartwater usually die within a week after the onset of the disease.
On rare occasions, heartwater appears as a subacute disease. In this form, the clinical signs include a prolonged fever, coughing, and mild incoordination. The animal either recovers or dies within 1 to 2 weeks. Mild or subclinical infections are seen in calves less than 3 weeks old, partially immune cattle or sheep, antelope, and some indigenous breeds of sheep and cattle. The only symptom is a transient fever. This form of the disease is known as ‘heartwater fever’. Cattle, sheep, goats, and wild buffalo are severely affected by heartwater, although in some indigenous African breeds of sheep and goats, the symptoms are mild. Blesbok, wildebeest, guinea fowl, leopard tortoises, and scrub hare are carriers.
E. ruminantium can also infect eland, springbok, antelope, white-tailed deer, ferrets, the striped mouse, the albino mouse, and the multimammate mouse.
Infectious Keratoconjunctivitis
Infectious Keratoconjunctivitis or Pinkeye caused by Moraxella bovis is one of the most common bovine ocular diseases. Cattle are the only reservoir for M. bovis. Infectious Keratoconjunctivitis of cattle, sheep, and goats is characterized by blepharospasm, conjunctivitis, lacrimation, and varying degrees of corneal opacity and ulceration. Corneal ulceration starts in the center of the cornea. Synechia and glaucoma can follow an acute attack. Most other ocular infections of cattle are characterized by conjunctivitis and minimal or absent keratitis.
The primary differential diagnosis is infectious bovine rhinotracheitis (IBR), which causes severe conjunctivitis and edema of the cornea near the corneoscleral junction, but corneal ulceration is uncommon. Other organisms that may cause conjunctivitis of cattle, either alone or in conjunction with M. bovis , include Mycoplasma spp and Neisseria spp. Infection with IBR or other microbes may increase the severity of infection with M bovis. In sheep, infection with Chlamydophila pecorum is most common.
Non-chlamydophilal infections may be caused by rickettsia-like organisms (Colesiota conjunctivae), Mycoplasma spp, and aerobic bacteria, notably Neisseria ovis. In goats, mycoplasmal infections are most common, although aerobic bacteria also have been isolated. Although much of the syndrome in young goats is caused by Mycoplasma agalactiae. In all species, presumptive diagnosis is based on ocular signs and concurrent systemic disease. It is important to distinguish that the lesions are not due to foreign bodies or parasites.
Johnes Disease or Paratuberculosis in cattle
Affected cattle, sheep and goats develop progressive emaciation. The typical age of onset of obvious clinical signs various around 2 to 7 years. Cattle develop profuse, chronic, nonfetid diarrhea (no blood or fibrin), progressive weight loss, and submandibular and brisket edema. Chronic weight loss is the most common clinical sign in small ruminants, they do not commonly develop diarrhea but pasty unpelleted feces are occasionally noted. Appetite and rectal temperatures are normal in most cases. Subclinical disease exists for years before the affected animal shows the clinical signs of weight loss ± diarrhea. Subclinically affected dairy animals economically impact the herd by producing less milk than their unaffected herdmates.
Subclinical animals shed less organisms than clinically apparent cases, but still provide a source of infective organisms to other animals in the herd. The disease is caused by Mycobacterium paratuberculosis, a Gram positive, acid fast bacterial rod. Transmission is primarily by the oral-fecal route. The majority of infections occur shortly after birth when the animals are most susceptible. After 6 months of age, cattle become more resistant to infection, and a much higher dose is needed to cause infection. At least 25% of heavily infected cows spread the disease transplacentally to their fetuses, and shed organisms in their milk.
Once ingested, organisms invade the lamina propria of the ileum, cecum and colon, and slowly multiply. The organisms incite a granulomatous reaction (macrophages, lymphocytes) in the bowel, and spread to regional lymph nodes via infected macrophages. Subclinically affected animals shed low numbers of organisms compared to clinically affected animals. The disease consists of three stages.
Stage 1: prepatent
Stage 2: patent
Stage 3: clinical
Currently, there is not a reliable method of detecting subclinical infections in animals, so eradication of this disease is very difficult to accomplish. There is no practical and effective treatment, and infected animals should be culled for slaughter purposes. The progeny of infected cows are very likely to be infected.
Leptospirosis
Leptospirosis is recognized worldwide as a cause of abortion, systemic illness, and mastitis and is transmissible to man. Acute leptospirosis can be severe in calves. Calves may have fever, anorexia, dyspnea from pulmonary congestion, icterus, hemoglobinuria, and hemolytic anemia. Body temperature may rise suddenly to 105 to 106°F (40.5 to 41°C). Hemoglobinuria rarely lasts longer than 48 to 72 hours.
The anemia begins to improve by 4 to 5 days and returns to normal 7 to 10 days later. Morbidity and mortality are higher in calves than in adult cattle. In older cattle, signs vary greatly and diagnosis is more difficult. Signs usually are restricted to a sudden drop in milk production. The milk is thick, yellow, and blood-tinged, with thick clots and a high somatic cell count; milk production can drop 10 to 75%, depending on the infecting strain. The udder is typically soft and flabby, which is unique for leptospirosis. Milk production can return to normal in 10 to 14 days even in the absence of treatment.
However, cows with a severe drop in production may not recover to full production during that lactation cycle. Chronic forms of leptospirosis manifest as abortion and stillbirths. Abortion generally occurs 6 to 12 weeks after initial infection and is more common during the third trimester. An abortion storm in a breeding herd is often the first indication of leptospirosis infection, because the mild initial signs often pass unnoticed.
In endemically infected herds, abortions occur mostly in younger animals and are sporadic. Calves reared by previously infected cows are protected by colostral antibodies for up to 6 months. Infertility may also be a problem in endemically infected herds, possibly as a consequence of localization of infection in the uterus and oviducts.
Lumpy skin disease
Lumpy skin disease is also known as pseudo-urticarai, Neethling Virus Disease or Knopvelsiekte. It’s caused by a capripoxvirus and is characterized by the eruption of variably sized nodules on the skin, edema of one or more limbs, swelling of the lymph glands, and necrotic plaques in mucosae. Secondary problems include pneumonia and infertility. Lumpy skin disease is not highly contagious and has a low mortality rate. All ages of cattle can be affected, but young calves are usually more severely affected.
The severity of the disease depends on the dose of the inoculum as well as the susceptibility of the host (Bos taura is more susceptible than Bos indicus) and the route of exposure. A fever 104 to 107°F (40 to 41.5°C) can occur and can be transitory or last up to 4 weeks. Generally within 2 days after the appearance of the fever, swellings or nodules 1 to 5 cm in diameter appear in the skin and generalization occurs. Depression, anorexia, excessive salivation, oculonasal discharge, agalactia, and emaciation are presented. The hair stands erect over early skin lesions.
The nodules are painful and involve the epidermis, dermis, and subcutaneous tissue and may even involve the musculature. As the disease progresses, the nodules become necrotic, and eventually a deep scab forms; this lesion is called a sitfast. Here, extensive generalization occurs, animals can become lame and reluctant to move because of edema. Lameness also may result from inflammation of the tendons, tendon sheaths (tendosynovitis), joints (synovitis), and laminae (laminitis). Severe edema in the brisket and legs can occur.
If secondary bacterial infection develops in the tendon sheaths and joints, permanent lameness may result. Superficial lymph nodes such as the mandibular, parotid, prescapular, and prefemoral nodes, draining affected areas of skin become enlarged 4 to 10 times normal size. Abortion may occur as the result of prolonged fever. Temporary or permanent sterility in bulls can result from the fever or lesions of the reproductive organs. Cows may not come into estrus for several months after LSD. The lesions may persist in various stages over a course of 4 to 6 weeks. Final resolution of lesions may take 2 to 6 months, and nodules can remain visible 1 to 2 years. Permanent damage to the hide is inevitable in clinical cases.
Malignant Catarrhal Fever (MCF) or Snotsiekte
The African form of malignant catarrhal fever is due to alcelaphine herpesvirus-1. This virus is carried by wildebeest and the disease in cattle is often known as wildebeest-associated malignant catarrhal fever. This virus is not found in the North American or European form of the disease except in exotic ruminants in zoos. It is characterized by a necrotizing arteritis affecting many body systems. Affected cattle usually die within a week of onset of signs but some animal survive for extended periods with a chronic disease or recovery.
The agent of this form of malignant catarrhal fever is classified as ovine herpesvirus 2 (OvHV-2); subclinical bovine infection with the virus can occur. There are rare reports of necrotizing vasculitis associated with OvHV-2 in goats. Sheep are carriers of this form of malignant catarrhal fever and are often responsible for spreading the disease to cattle. Most affected cattle may have the following signs: fever, depression, diarrhea, anorexia, rhinitis with nasal discharge that becomes mucopurulent and encrusted.
The skin of the muzzle becomes eroded, and there is stomatitis, pharyngitis, laryngitis, and parotitis with salivation. Acute MCF cases caused by ovine herpesvirus-2 and alcelaphine herpesvirus-1 are similar clinically and pathologically. Disease course may range from peracute to chronic. Cases in deer are often peracute with sudden death. Deer that survive for a few days and bison usually develop hemorrhagic diarrhea, bloody urine, and corneal opacity before expiring. High fever (106 to 107°F [41 to 41.5°C]) and depression are common. Other signs that may be present include catarrhal inflammation; erosions and mucopurulent exudation affecting the upper respiratory, ocular, and oral mucosa; swollen lymph nodes; lameness; and CNS signs (depression, trembling, hyporesponsiveness, stupor, aggressiveness, convulsions).
In cattle, swollen lymph nodes and severe eye lesions (panophthalmitis, hypopyon, corneal erosions) are more frequent, and hemorrhagic enteritis and cystitis less frequent compared to deer and bison. Skin lesions (erythema, exudation, cracking, crust formation) are common in animals that do not succumb quickly. Up to 25% of cattle experience chronic disease, and sometimes the disease waxes and wanes. Most eventually die, but about 5% clinically recover.
Mucosal Disease (MD)
Mucosal Disease (MD) is a highly fatal form of BVD that may be acute or chronic and is seen infrequently in persistently infected cattle. MD is induced when persistently infected cattle become superinfected with cytopathic BVDV. The origin of the cytopathic BVDV is usually internal, resulting from a mutation of the resident persistent, noncytopathic BVDV. In those cases, the cytopathic virus is antigenically similar to the resident noncytopathic virus.
External origins for cytopathic BVDV include other cattle and modified live virus vaccines. Cattle that develop MD due to exposure to a cytopathic virus of external origin often produce antiviral antibody. Prevalence of persistent infection usually is low, and many persistently infected cattle do not develop MD, regardless of exposure.
Acute MD is characterized by fever, leukopenia, dysenteric diarrhea, inappetence, dehydration, erosive lesions of the nares and mouth, and death within a few days of onset. Clinical signs of chronic mucosal disease may last several weeks to months and are less severe than those of acute mucosal disease. Intermittent diarrhea and gradual wasting are common. Coronitis and eruptive lesions on the skin of the interdigital cleft cause lameness in some cattle.
Neosporosis
Neosporosis has been recognized in dogs, cattle, sheep, goats, deer, horses, and experimentally rodents, pigs, monkeys, and cats. The protozoan Neospora Caninum is a major cause of abortion in cattle and congenital infection in calves. Aborted tissue typically has multifocal gliosis and malacia in central nervous tissue, myocardial necrosis, mononuclear myocarditis and multifocal placentitis.
Bovine abortions appear to be most common after 90 days of gestation with a peak at 5 to 7 months. N. caninum has also been associated with abortion in sheep and goats but natural infection is uncommon. N caninum is present in most countries. Calves may be aborted; stillborn; born underweight, weak, or paralyzed; or they may become paralyzed within 4 weeks of birth. Abortion can occur throughout gestation, and some cows may abort again; dams of these calves are clinically normal.
Pneumonic Pasteurellosis
Mannheimia haemolytica and Pasteurella multocida are the most common bacteria found in bovine pneumonia. Pneumonia often follows stress such as shipment (shipping fever) and is common in young calves. Clinical signs of bacterial pneumonia are often preceded by signs of viral infection of the respiratory tract. With the onset of bacterial pneumonia, clinical signs increase in severity and are characterized by depression and toxemia.
Fever (104 to 106°F [40 to 41°C]); serous to mucopurulent nasal discharge; moist cough; and a rapid, shallow respiratory rate may be noted. Auscultation of the cranioventral lung field reveals increased bronchial sounds, crackles, and wheezes. In severe cases, pleuritic may develop, characterized by an irregular breathing pattern and grunting on expiration. The animal will become unthrifty in appearance if the pneumonia becomes chronic, which is usually associated with the formation of pulmonary abscesses. Diagnosis relies on bacterial culture.
Because the bacteria involved are normal inhabitants of the upper respiratory tract, the specificity of culture can be increased by collecting antemortem specimens from the lower respiratory tract.
Pseudocowpox
Pseudocowpox is a viral skin disease that causes mild sores on the teats and udders of cattle. This virus can also infect humans and the condition is commonly referred to as milker’s nodule. Its caused by a parapoxvirus related to the orf and papular stomatitis viruses. The initial signs of pseudocowpox are small, reddish, raised sores on the teats and udders of cows.
This is followed by the formation of vesicles, scabs, and nodules on the udder and teats. The extension of sores often forms a “ring” or “horseshoe” of scabs that are characteristic for pseudocowpox and this occurs over the course of several weeks. Although the disease spreads slowly through milking herds, it is common for the entire herd to eventually be affected. The length of immunity after infection is usually short and reinfection is common.
Scabs may be abundant but can be removed without causing pain. Some lesions persist for several months, giving the affected teats a rough feel and appearance, and more scabs may form. The scabbed lesions may be confused with mild traumatic injuries to the teats and udder. Scabs examined with an electron microscope frequently show characteristic virus particles.
Q Fever
Q fever is a zoonotic bacterial infection associated primarily with parturient ruminants caused by Coxiella burnetti. Q fever occurs more frequently in persons with occupational contact with high-risk species. It has a highly variable clinical presentation in humans, ranging from a self-limiting influenza-like illness to pneumonia, hepatitis, and endocarditis. It is highly infectious, and a single organism can reportedly cause infection via the aerosol route in humans. Q fever is considered a potential agent of bioterrorism due to its high rate of infectivity, stability in the environment, and potential for aerosol dispersion. C. burnetii can infect many species of domesticated animals and wildlife; in many species, the infection appears to be asymptomatic.
Its reservoirs may be only partially known. Sheep, goats and cattle seem to be the most common domesticated animal reservoirs. Wild rodents may be important reservoirs in some areas, and cats are suspected in urban outbreaks. C. burnetii has also been isolated from dogs, rabbits, horses, pigs, camels, buffalo, deer, pigeons, swallows, parrots, crows, geese and other mammals and birds. Infection in ruminants is usually subclinical but can cause anorexia and late abortion. Reports have implicated C burnetii as a cause of infertility and sporadic abortion with a necrotizing placentitis in ruminants. In the picture, the intercotyledonary placenta is thickened, opaque, and multifocally covered by tan clumps of exudate. Margins of several cotyledons are tan (necrosis), and centers are mottled red-brown (congestion and exudation).
Rabies
Rabies is a disease of mammals caused by a member of the Lyssavirus genus of the Rhabdovirus family. Diagnosis is confirmed by identification of the virus by public health officials. Rabies is an acute viral encephalomyelitis that principally affects carnivores and bats, although it can affect any mammal. It is invariably fatal once clinical signs appear. Rabies is found throughout the world.
Rabid animals of all species usually exhibit typical signs of CNS disturbance, with minor variations among species. The most reliable signs, regardless of species, are acute behavioral changes and unexplained progressive paralysis. Behavioral changes may include sudden anorexia, signs of apprehension or nervousness, irritability, and hyperexcitability (including priapism). Ataxia, altered phonation, and changes in temperament are apparent. Uncharacteristic aggressiveness may develop—a normally docile animal may suddenly become vicious.
Commonly, rabid wild animals may lose their fear of humans, and species that are normally nocturnal may be seen wandering about during the daytime. The clinical course may be divided into 3 phases—prodromal, excitative, and paralytic/endstage. However, this division is of limited practical value because of the variability of signs and the irregular lengths of the phases. During the prodromal period, which lasts about 1 to 3 days, animals show only vague CNS signs, which intensify rapidly. The disease progresses rapidly after the onset of paralysis, and death is virtually certain. Some animals die rapidly without marked clinical signs. The term “furious rabies” refers to animals in which aggression (the excitative phase) is pronounced. “Dumb or paralytic rabies” refers to animals in which the behavioral changes are minimal, and the disease is manifest principally by paralysis.
Cattle with furious rabies can be dangerous, attacking and pursuing humans and other animals. Lactation ceases abruptly in dairy cattle. The usual placid expression is replaced by one of alertness. The eyes and ears follow sounds and movement. A common clinical sign is a characteristic abnormal bellowing, which may continue intermittently until shortly before death. In general, rabies should be suspected in terrestrial wildlife acting abnormally.
Rift Valley Fever
A Phlebovirus of the familiy Bunyaviridae is the viral agent of Rift Valley Fever (RVF), an arthropod-borne viral disease seen in Africa and the Arabian Peninsula that can cause high mortality particularly in new-born lambs and children and abortion in adult sheep, goats and cattle. This virus causes a hemorrhagic fever syndromes in humans. RVF is a peracute or acute zoonotic disease of domestic ruminants in Africa and the Arabian Peninsula. Signs of the disease tend to be nonspecific, rendering it difficult to recognize individual cases. During epidemics, the occurrence of numerous abortions and deaths among young animals, together with an influenza-like disease in humans, tends to be characteristic.
The most common form of the disease is a self-limiting, flu-like illness; however, ocular disease and rare cases of fatal hemorrhagic fever also occur. RVF can affect many species of animals including sheep, cattle, goats, buffalo, camels, and monkeys, as well as gray squirrels and other rodents. The primary amplifying hosts are sheep and cattle. Viremia without severe disease may be seen in adult cats, dogs, horses and some monkeys, but severe disease can occur in newborn puppies and kittens. Rabbits, pigs, guinea pigs, chickens and hedgehogs do not become viremic.
RVF should be suspected when abnormally heavy rains are followed by the widespread occurrence of abortions and mortality among newborn animals characterized by necrotic hepatitis, and when hemorrhages and influenza-like disease are seen in people handling animals or their products.
In the picture the skin of this emphysematous fetus is stained with meconium.
Rinderpest (RP)
Rinderpest is an acute, highly contagious, fatal viral disease of cattle, buffalo and wild ruminants manifested by inflammation, haemorrhage, erosions of the digestive tract, wasting and often bloody diarrhea. It is caused by a Morbillivirus that produces economically-devastating highly-fatal outbreaks. The classical form of rinderpest is one of the most lethal diseases of cattle, and can have a catastrophic effect on naïve herds.
At one time, epidemics of rinderpest occurred regularly in Eurasia. In 1889, cattle shipped from India carried the rinderpest virus to Africa, causing an epidemic that established the virus on the continent. Initially, approximately 90% of the cattle in sub-Saharan Africa and many sheep and goats died. Wild buffalo, giraffe and wildebeest populations were decimated. The loss of plow animals, herds and hunting resulted in mass starvation, killing a third of the human population in Ethiopia and two-thirds of the Maasai people of Tanzania. As of 2008, two of the three known rinderpest lineages have been eradicated. The third lineage may also have vanished, although there is a possibility that it may persist in pockets in Africa.
If a rinderpest outbreak were to occur now, particularly outside Africa, it would be of tremendous significance. Clinical and pathologic findings may be sufficient for diagnosis in endemic areas and after initial laboratory confirmation of an outbreak. The carcass derived from a feverish and debilitated animal showing the sign of acute disease on antemortem examination should be condemned.
Schmallenberg virus
Schmallenberg virus is an emerging disease of the Orthobunyavirus group in Bunyaviridae family. Adult cattle tend to show mild to moderate disease of short duration. Milk drop, diarrhea and pyrexia may be noticed. Adult sheep seem to show less to no signs. On the other hand signs in adult sheep seemed to be missed more due to less intense supervision as in dairy cattle.
There may be abortion in the later stages of pregnancy or defects in newborn calves and lambs. These defects could be exhibited as brain, limb or spinal cord malformations or nervous system damage such as ataxia, blindness, inability to nurse or stand and occasional convulsions.
Arthrogryposis is an SBV associated deformation. Due to some malformation of the newborns, the mother animal can suffer from extensive birth canal damage. Farmers are encouraged to contact their veterinarians in cases of stillbirths or fetal malformations or nervous system signs. Veterinarians in turn should contact their laboratory if they suspect Schmallenberg virus infection.
Shipping fever pneumonia
Shipping fever pneumonia is a respiratory disease of cattle of multifactorial etiology with Mannheimia haemolytica and, less commonly, Pasteurella multocida or Histophilus somni, being the important infectious agents involved. Disease is typically seen in feeder calves 7 to 10 days after assembly in a feedlot. Morbidity can approach 35% and mortality is 5 to 10%.
The pathogenesis of shipping fever pneumonia involves stress factors, with or without viral infection, interacting to suppress host defense mechanisms, which allows the proliferation of commensal bacteria in the upper respiratory tract. Subsequently, these bacteria colonize the lower respiratory tract and cause a bronchopneumonia with a cranioventral distribution in the lung.
Multiple stress factors are believed to contribute to the suppression of host defense mechanisms. Transportation over long distances serves as a stressor; it may be associated with exhaustion, starvation, dehydration, chilling and overheating depending on weather conditions, and exposure to vehicle exhaust fumes. Additional stressors include passage through auction markets; commingling, processing, and surgical procedures on arrival at the feedlot; dusty environmental conditions; and nutritional stress associated with a change to high-energy rations in the feedlot.
Tickborne fever or pasture fever
Tickborne fever (TBF) is caused by Anaplasma phagocytophilum that invade neutrophils and monocytes. Transmitted by the tick Ixodes ricinus and has been reported in Europe, India and South Africa. There can be fever and leukopenia with other signs absent or mild, but infection predisposes animals to other diseases. The main hosts are sheep and cattle, but goats and deer are also susceptible. After infestation with infected ticks, the incubation period may be 5 to 14 days, but after injection with infected blood, the incubation period is 2 to 6 days.
In sheep, the main clinical sign is a sudden fever (105 to 108°F [40.5 to 42.0°C]) for 4 to 10 days. In cattle, the disease occurs as an annual minor epidemic when dairy heifers and cows are turned out to pasture in the spring and early summer. Within days, the cows are dull and depressed, with a marked loss of appetite and milk yield. Affected cows usually suffer from respiratory distress and coughing. Clinical signs are more obvious and last longer in newly purchased animals than in home-bred animals. Abortions affect susceptible ewes and cows newly introduced onto tick-infested pastures during the last stages of gestation, with abortions occurring 2 to 8 days after the onset of fever.
Except for aborting ewes, death due to TBF is rare. Variations in severity of the clinical effects may be related to differences between strains of A phagocytophilum or in host susceptibility. Perhaps the most significant effect of TBF infection is its serious impairment of humoral and cellular defense mechanisms, which results in increased susceptibility to secondary infections such as tick pyemia, pneumonic pasteurellosis, louping ill, and listeriosis.
Tuberculosis
Tuberculosis (TB) is an infectious, granulomatous disease caused by acid-fast bacilli Mycobacterium bovis. Although commonly defined as a chronic, debilitating disease, TB occasionally assumes an acute, rapidly progressive course. The disease affects practically all species of vertebrates, and before control measures were adopted, was a major disease of humans and domestic animals. Bovine TB is still a significant zoonosis in many parts of the world. Signs and lesions are generally similar in the various species.
The clinical signs reflect the extent and location of lesions plus the underlying toxemia. Generalized signs include progressive emaciation, lethargy, weakness, anorexia, and a low-grade, fluctuating fever. The bronchopneumonia of the respiratory form of the disease causes a chronic, intermittent, moist cough with later signs of dyspnea and tachypnea. The destructive lesions of the granulomatous bronchopneumonia may be detected on auscultation and percussion. Superficial lymph node enlargement may be a useful diagnostic sign when present.
Affected deeper lymph nodes cannot always be palpated, but they may cause obstruction of the airways, pharynx, and gut, leading to dyspnea and ruminal tympani. The single most important diagnostic test for TB is the intradermal tuberculin test.
Vesicular stomatitis
Vesicular stomatitis is caused by Vesiculoviruses in the family Rhabdoviridae. Vesiculation, ulceration, and erosion of the oral and nasal mucosa and epithelial surface of the tongue, coronary bands, and teats are typically observed in clinical cases, along with crusting lesions of the muzzle, ventral abdomen, and sheath. Clinical disease has been observed in cattle, horses, and pigs and very rarely in sheep, goats, and llamas. The viruses are zoonotic and may cause influenza-like disease in people working in close contact with the virus.
The incubation period is 2 to 8 days and is typically followed by a fever. Ptyalism is often the first sign of disease. Ulcers and erosions on the teats are not uncommon in cattle and may result in secondary cases of mastitis in dairy cows. Coronitis with erosions at the coronary band are observed in cattle, horses, and pigs with subsequent development of lameness. Loss of appetite due to oral lesions and lameness due to foot lesions are normally of short duration, as the disease is generally self-limiting with complete resolution within 10 to 14 days. Virus neutralizing antibodies to either serotype persist, potentially for 5 years, but reinfection can occur following a second exposure. In most areas vesicular stomatitis is a reportable disease.
Samples for diagnostic purposes are generally taken by regulatory veterinarians and are tested by government laboratories. Of primary concern in diagnosis is differentiation of vesicular stomatitis from more devastating viral diseases including foot-and-mouth disease, swine vesicular disease, and vesicular exanthema of swine.